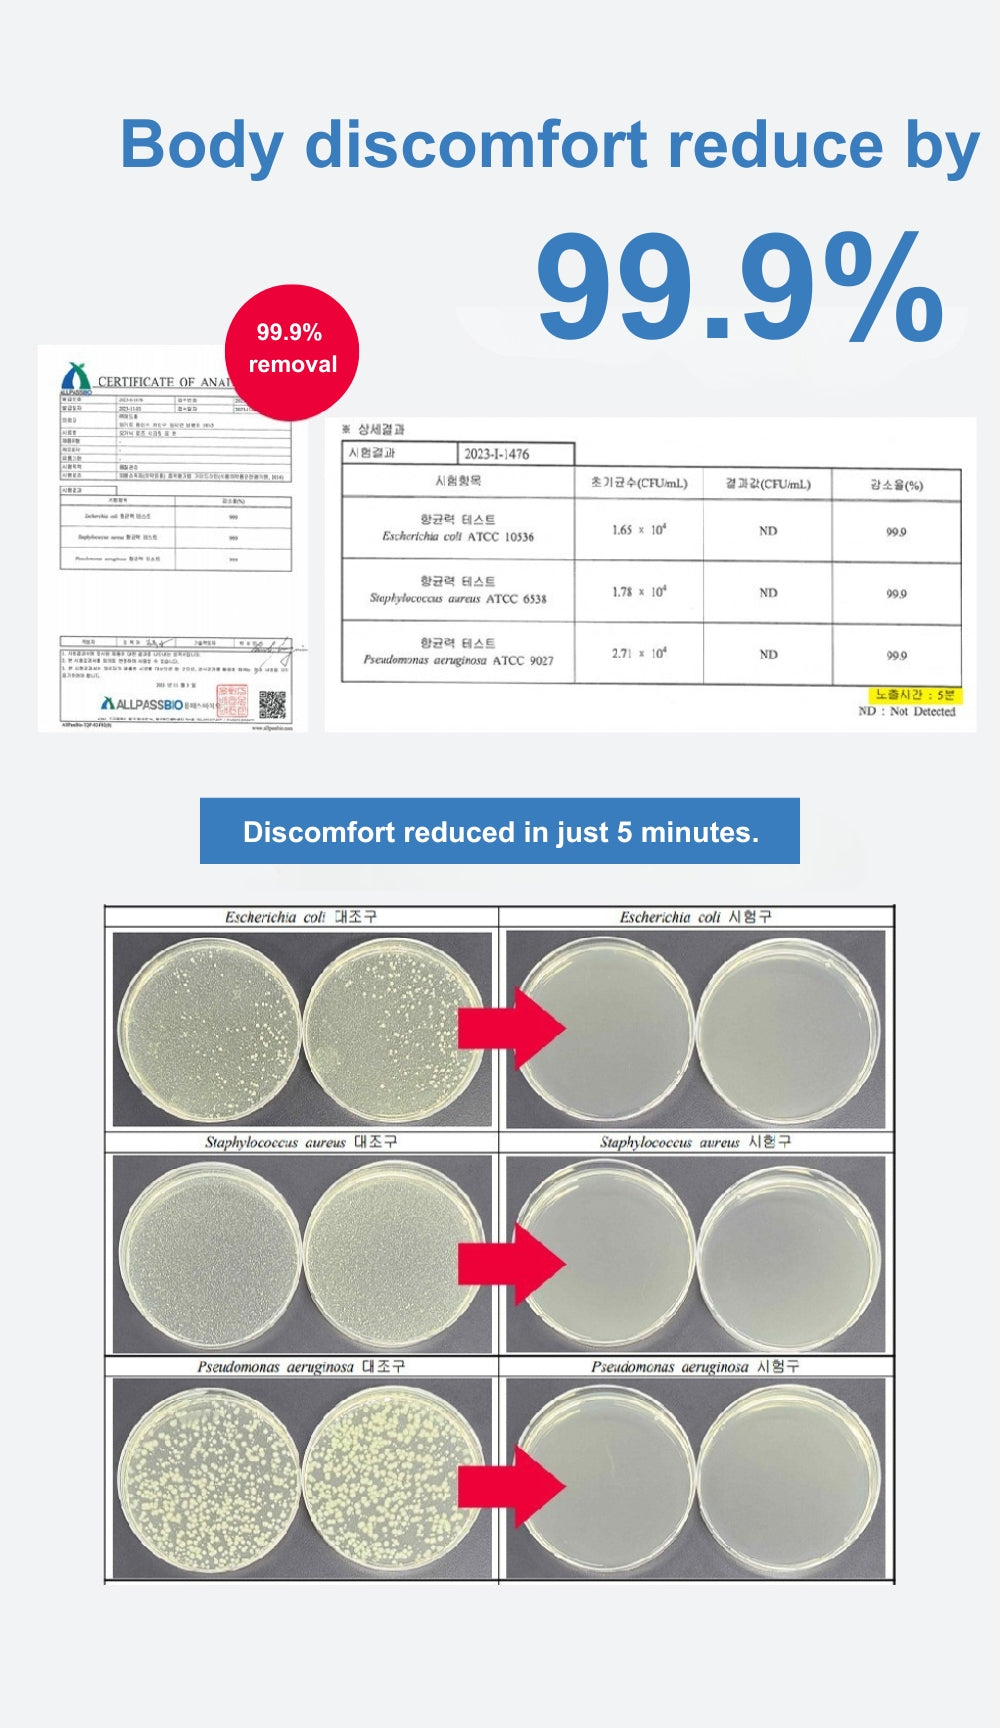

The Aroma Shop Organic Rose Secret Cooling Mist (100ml)
Experience ultimate freshness and confidence with The Aroma Organic Rose Secret Cooling Body Mist. This gentle formula not only maintains intimate hygiene but also offers a subtle, captivating fragrance. Let the delicate floral notes surround you, providing all-day comfort with a hint of refined elegance.

The Aroma Shop Organic Rose Secret Cooling Mist (100ml)
Sale priceRM79.00
Regular priceRM79.00 (/)
Organic Mist
Gorgeous Jo
The Aroma Shop Organic Rose Secret Feminine Mist (100ml)
Sale priceRM79.00
Gorgeous Jo
The Aroma Shop Organic Rose Hair Mist
Sale priceRM79.00
Gorgeous Jo
The Aroma Shop Organic Tea Tree Acne Mist (100ml)
Sale priceRM79.00
Gorgeous Jo
The Aroma Shop Organic Foot Mist
Sale priceRM79.00